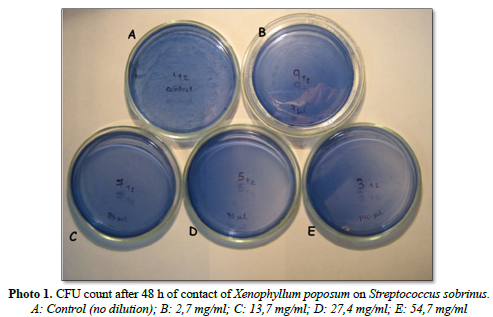

1101
Views & Citations101
Likes & Shares
Xp ES was diluted in BHI broth until concentrations of 54.7, 27.4, 13.7 and 2.7 mg/ml were obtained. Then, a constant amount of inoculum of each microbial strain was seeded, previously adjusted to the turbidity of the tube 0.5 of the Mc Farland scale. OD560 nm was measured at 0, 24, 48 and 72 h to determine MIC. It was seeded on selective solid media to perform colony counts which were expressed in log CFU/ml, thus determining the MBC. A growth control of the microorganism without the inhibitory substance (control) was performed. All tests were performed in duplicate. ANOVA and Kruskal Wallis tests were used for statistical analysis of the data.
Results: the ethanolic extract of Xenophyllum poposum inhibits the growth of all the microorganisms analyzed in this work (MIC; 2.7 mg/ml for S. sobrinus and 13.7 mg/ml for Sm, Lac, Ao and An. The concentrations necessary to produce the death of Ss was 13.7 mg/ml. Gram-positive bacilli, such as Lactobacillus and Actinomyces, as well as Sm, required higher concentrations (27.4 mg/ml).
This work points to the use of this regional natural substance as an alternative treatment in the prevention of dental caries.
Subsidized by the Research Council of the UNT.
Keywords: Xenophyllum poposum, Caries, Natural substances, Prevention, CIM & CBM
Abbreviations: MIC: Minimum Inhibitory Concentration; MBC: Minimum Bactericidal Concentration; Xp: Xenophyllum poposum; Sm: Streptococcus mutans; Ss: Streptococcus Sobrinus; Lc: Lactobacillus casei; Ao: Actinomyces odontolyticus; An: Actinomyces naeslundii; BHI: Brain Heart Infusion; AR: Rogosa Agar; Cl: Chlorhexidine
Dental caries is a multifactorial dysbiosis characterized by localized demineralization of dental tissue by acids produced by microbial fermentation of dietary carbohydrates [3]. That is, when ecological changes occur in the balance of the microbiota, for example repeated drops in pH as a consequence of carbohydrate consumption, the proliferation of cariogenic microorganisms is favored with the balance tipping towards demineralization [4].
Among the various microorganisms that are directly related to dental caries are the Streptococcus mutans group, Lactobacillus and Actinomyces [5].
Bacteria of the genus Streptococcus and Actinomyces possess fimbriae, which allow them to adhere to dental elements and interact with other bacteria. In addition, they produce intra- and extracellular polysaccharides that contribute to the formation of the biofilm matrix; and they possess enzymes that allow them to ferment dietary carbohydrates and are acidogenic and aciduric [6]. They fulfill, therefore, an important role in the development of the initial lesions of dental caries.
The genus Lactobacillus is considered a secondary colonizer of the biofilm of supragingival bacterial plaque due to the lack of adhesion systems, therefore, they are not considered primary etiological agents of caries, but they intervene in the progression of the disease thanks to their great acidogenic, acidophilic and aciduric capacity and also, thanks to their proteolytic power they intervene in dentinal caries [7]. The most numerous species of this genus in the oral cavity is Lactobacillus casei.
Based on the above, the current preventive treatment of caries is focused on the control (and not the complete elimination) of microbial biofilm mechanically with brushing and regular use of dental floss, together with the use of antimicrobial agents and avoiding fermentable carbohydrates between meals [8,9].
There is a wide variety of chemical anti-bacterial plaque agents, among which we find broad-spectrum antiseptics such as phenolic compounds and bis-guanides [10]. Chlorhexidine (CL), a bis-guanide currently used in the control of bacterial plaque biofilm, is one of the most efficient antimicrobial agents in this regard. It possesses some adverse effects such as: dental staining, unpleasant taste, taste alteration and mucosal erosion [11].
Medicinal plants have been used since primitive times in the treatment of diseases since they present multiple physiological effects, due to the fact that they possess more than one active principle by the presence of different chemical compounds specific to the plant that are subjected to a series of physical variables such as: soil moisture, light conditions, temperature, environmental factors, among others. These compounds are also called secondary metabolites. The standardization of these variables, the quality control in their elaboration and the clinical results observed in research works allow the use of medicinal plants with scientific support, since, otherwise, they would represent a health risk [12].
In the dental field, research on the antimicrobial activity of plant extracts is stimulated in order to help in the control of biofilm and decrease the incidence of dental caries and periodontal disease [13].
In this work, we proposed to validate the traditional use as antimicrobial of Xenophyllum poposum, which grows in the high mountains of northwestern Argentina and the antecedents found in the literature suggest a possible antimicrobial action [14]. However, in the dental field, no studies have been reported that support its effectiveness on oral pathogens.
The antimicrobial activity of substances against a microorganism can be evaluated through qualitative and quantitative methods, described by the National Committee for Clinical Laboratory Standards (NCCLS 2003). Quantitative methods include the determination of the Minimum Inhibitory Concentration (MIC), which consists of establishing the lowest concentration of an antibiotic capable of visibly inhibiting the growth of a microorganism; and the Minimum Bactericidal Concentration (MBC), which is the minimum concentration of antibiotic capable of killing a given microorganism. This can be done using two techniques considered reference techniques: the agar dilution technique and broth dilution [15]. Qualitative methods are those that, using the diffusion of a specific antimicrobial concentrated on a paper disk, allow the categorization of microorganisms into sensitive, intermediate or resistant. These categories must be well interpreted by physicians and laboratory personnel due to their clinical significance [16].
OBJECTIVES
Therefore, the objective of this work was to determine the Minimum Inhibitory Concentration (MIC) and Minimum Bactericidal Concentration (MBC) of the ethanolic extract of Xenophyllum poposum on the following cariogenic microorganisms: Streptococcus mutans, Streptococcus sobrinus, Lactobacillus casei, Actinomyces naeslundii and Actinomyces odontolyticus.
MATERIALS AND METHODS
A descriptive type of research was carried out based on systematic observation. The design was experimental and comparative in which the effect of different concentrations of the ethanolic extract of Xenophyllum poposum on the growth of Streptococcus mutans (Sm), Streptococcus sobrinus (Ss), Lactobacillus casei (Lc), Actinomyces naeslundii (An), and Actinomyces odontolyticus (Ao) was evaluated at different times, compared with the growth of the strain without the phytotherapic (control group). A 24-h active culture of each of the microorganisms was used.
The determination of the Minimum Inhibitory Concentration (MIC) was performed by the broth dilution method [15].
The reference specimen of Xenophyllum poposum was deposited in the herbarium of the Instituto Miguel Lillo (LIL 29301), Tucumán, Argentina [14]. Based on previous studies developed by our working group [17] the ethanolic extract of X. poposum was chosen for the present determinations. The concentration of the extract was 1190 mg/ml, and from this the corresponding dilutions were made in Brain Heart Infusion (BHI) broth, which was the liquid medium used for MIC determination. For the determination of MBC, Mitis Salivarius agar with Bacitracin (MSB) was used for Streptococcus, Rogosa agar (RA) for Lactobacillus and Thioglycollate agar (TGA) for Actinomyces. The Anova and Kruskal-Wallis tests were used for statistical analysis of the data.
For MIC determination, equal amounts of BHI broth were placed in a series of tubes. In one of them, the growth control of the microorganism was performed, without the phytotherapeutic agent. In the remaining tubes, decreasing dilutions of the pure ethanolic extract of X. poposum were placed. The following concentrations were obtained: 54.7 mg/ml, 27.4 mg/ml, 13.7 mg/ml and 2.7 mg/ml.
They were then inoculated with 5 l of the active cultures of S. mutans, S. sobrinus, L. casei, A. naeslundii and A. odontolyticus, which were previously adjusted to tube turbidity 0.5 of the Mc Farland scale. All tests were performed in duplicate.
To determine the MBC, aliquots of 5 l from each of the tubes were inoculated from the liquid cultures into Petri dishes with 10 ml of the aforementioned culture media for each of the microorganisms.
The liquid media and agar plates were incubated at 37 ºC, in the presence of air and 5% CO2, i.e., in facultative anerobiosis. To determine the MIC, Optical Density (OD 560 nm) readings were taken and compared with the normal growth curve of each microorganism without the antimicrobial under study.
To determine the MBC, viable bacteria were counted in each box at 0, 24, 48 and 72 h of incubation. The results were expressed in log CFU/ml of medium (Figure 1).

RESULTS
Under the conditions of this test and according to the statistics, the lowest concentration of the ethanolic extract of X. poposum capable of inhibiting the growth of Streptococcus mutans was the concentration of 13.7 mg/ml (Figure 2). It can be observed in this graph that with the ethanolic extract concentration of 2.7 mg/ml a behavior similar to the control is observed, with a clear phase of exponential growth of the microorganism that continues until after 48 h. With higher concentrations of the extract, the growth curve is maintained at basal levels and according to the statistics the MIC corresponds to the concentration of 13.7 mg/ml with a p value=0.036. Confidence interval: 95%.

The lowest concentration of the ethanolic extract of Xenophyllum poposum capable of killing Streptococcus mutans was 27.4 mg/ml (p=0.024). For lower concentrations no statistically, significant differences were found under the conditions of this assay. In Figure 3 we can see that with concentrations of 2.7 and 13.7 mg/ml, although lower CFU counts than the control is obtained, there is no considerable drop in the counts, even at 72hs. With higher concentrations, after 72 h, no viable microorganisms are observed.

Under the conditions of this assay and according to the statistics, the Minimum Concentration of the ethanolic extract of X. poposum capable of inhibiting the growth of the microorganism under study was 2.7 mg/ml (p=0.046).
In coincidence with what was observed in the previous Graph (No. 3), this Figure 4 shows the greater sensitivity of S. sobrinus with respect to S. mutans. The concentration of 13.7 mg/ml produced the death of the microorganism after 24 h of incubation, being the difference statistically significant with respect to the control (p=0.022), as with the higher concentrations (27.4 mg/ml and 54.7 mg/ml). It can also be observed in Figure 5 that even the concentration of 2.7 mg/ml also produced the death of this microorganism, but after 72 h of incubation.


As shown in Figure 6, the lowest concentration of the ethanolic extract of X. poposum capable of inhibiting the growth of Lactobacillus casei corresponds to a concentration of 13.7 mg/ml. The statistical analysis of the OD data provided a value of p= 0.0216. According to the statistical report of the OD data, with the concentration of 27.4 mg/ml similar results were obtained, a situation that is also observed in the graph. With the concentration of 54.7 mg/ml, the decrease in OD at 48 h was greater.

At a concentration of 27.4 mg/ml of the ethanolic extract of X. poposum, we see that there are no viable cells of L. casei at 72 h (p=0.038). For lower concentrations no statistically, significant differences were found with respect to the control. The concentration of 54.7 mg/ml produced the death of the microorganism in a shorter time (48 h); Figure 7 clearly shows the drop of CFU to 0, but the difference in this time between the concentration of 27.4 mg/ml and the concentration of 54.7 mg/ml was not statistically significant (p=0.213), therefore, the concentration of 27.4 mg/ml was taken as CBM.

When analyzing the curve of the optical density 560nm of A. naeslundii as a function of time, we can see that with the concentration of 2.7 mg/ml a decrease in OD was already observed, but with the concentration of 13.7 mg/ml statistically significant differences were found with respect to the control (p=0.045), that is to say that the Minimum Concentration of the ethanolic extract of X. poposum capable of inhibiting the growth of A. naeslundii was 13.7 mg/ml (Figure 8).

The Minimum Bactericidal Concentration of the ethanolic extract of X. poposum for A. naeslundii was 27.4 mg/ml. The p value was 0.018 at 48 h for this concentration, very similar to that obtained for the concentration of 54.7 mg/ml. With lower concentrations there were no significant differences with respect to the control (Figure 9).

Under the conditions of this assay, significant inhibition of the development of A. odontolyticus was achieved with concentrations of 13.7 mg/ml of the ethanolic extract of X. poposum (p=0.037). With the concentration of 2.7 mg/ml the microorganism showed a behavior similar to the control in terms of optical density 560 nm; while the concentrations of 27.4 and 54.7 mg/ml did not allow the increase of the turbidity of the culture. As clearly observed in the graph, the growth curve of this microorganism remains at levels close to 0.18, which corresponds to the optical density value of the freshly inoculated tubes (Figure 10).

As can be seen in Figure 11, at 24 h of incubation, with all concentrations of X. poposum the number of CFU remained practically unchanged; there was a sharp decrease in the number of CFU at 48 h with the concentrations of 27.4 and 54.7 mg/ml. The MBC of the ethanolic extract of X. poposum for Actinomyces odontolitycus was accordingly 27.4 mg/ml at 48 h (p=0.026). At lower concentrations, no significant changes in the number of CFU were obtained; this situation is reflected in the graph and was also observed in the statistical analysis, since at 72 h the number of CFU did not differ too much from the control.

In Photo 1 we observe the CFU of S. sobrinus in box A (control). In the following boxes, no more CFU of S. sobrinus are observed after 48 h of incubation.
In Photo 2 we observe in box L. casei control, that is, without the X. poposum extract, which at 48 h was seeded without prior dilution, and a large amount of CFU is observed after incubation. Box B was also seeded undiluted and shows only a few CFU of L. casei. In box C there is only one colony of L. casei and no growth of this microorganism in box D corresponding to the concentration of 27.4 mg/ml (CBM).

DISCUSSION
Kumar [18] worked with extracts of Indigofera trita on pathogenic strains and performed procedures similar to ours in terms of obtaining the extracts and selecting the extract with the highest activity. However, they determined the MIC by the agar diffusion method with discs impregnated with different concentrations of the substance to be studied. We prefer this technique since, due to the nature of the extract, they would have suffered greater evaporation in the discs.
Other authors Struthers and Westran [19] maintain that the MIC in a tube (dilution in broth) is considered to be the fundamental parameter for testing the sensitivity of a bacterium to an antibacterial. For this reason, it is the most reliable technique to determine the antimicrobial properties of a substance.
Devienne and Raddi [20] used the microplate method to evaluate the MIC of different antibiotics such as chloramphenicol, ampicillin and paepalantine. In the microplates, the precipitate of microbial cells is observed at the bottom of the plates and the MIC corresponds to the concentration at which this precipitate is not observed. This technique has the advantage of using a small volume of culture medium, is easily reproducible and allows testing a large number of samples at the same time.
In this work we used the determination of the MIC by the dilution method since it allows us, by means of OD readings, to have information on the growth curve of the microorganism in the presence of the inhibitory substance, to compare them statistically with the controls and to carry out sowings in agar of the tubes that are kept perfectly sterile, to determine the Minimum Bactericidal Concentration. With microplates there is a greater risk of contamination for subsequent studies. The determination of MIC by the dilution method coincides with the work done by Pieri [21] where the inhibitory activity of copaiba oil (Copaifera officinalis) against Streptococcus mutans was evaluated by serial dilution in broth. They also found good inhibitory action by Copaifera on S. mutans [21] as well as the activity of X. poposum found in this work.
The culture medium used by most authors for the agar diffusion method and for MIC and MBC determinations was Mueller Hinton, as it is established by Clinical and Laboratory Standards Institute (2007) [22]. In the works carried out with oral microorganisms, good results are not obtained with this culture medium since oral microorganisms have particular requirements and are very demanding in their development.
Better results are obtained with selective culture media such as those used in this work. This agrees with other studies carried out with phytotherapeutics on oral microorganisms in which selective culture media were also used [23].
Sybiya [24] studied through various mechanisms, the inhibitory potential of Quorung Sensing in biofilm formation by the action of cumin, a plant used as a condiment in the food industry. They argued that, using concentrations lower than the MIC, it was possible to nullify the antibacterial effect and achieve inhibition of the signal molecules responsible for microbial communication in the biofilm; decreasing for example the initial adhesion of microorganisms, interfering in the formation of exopolysaccharides necessary for matrix formation and preventing the maturation of the biofilm, resulting in defective biofilms.
It would be interesting, in further work, to study whether this property is also present in Xenophyllum poposum, considering that the biofilm of bacterial plaque is responsible for dental caries and also considering that currently we are trying to achieve an ecological balance in the oral cavity to prevent the establishment of pathogenic strains.
As for the way in which Xenophyllum poposum extract could be used, it would be important to incorporate it in different vehicles, so that it can be used as mouthwashes to reduce the number of cariogenic microorganisms in the entire oral cavity. It would also be important to include it in the form of gels that can be applied topically to specific lesions of the oral mucosa. Thus, the way is open for the study of new properties and forms of presentation of Xenophyllum poposum.
CONCLUSION
The ethanolic extract of the regional variety of Xenophyllum poposum tested in our laboratory inhibits the growth of all the microorganisms analyzed in this work and, at higher concentrations, produces their death.
The concentrations necessary to kill the genus Streptococcus sobrinus was 13.7 mg/ml. Gram-positive bacilli such as Lactobacillus and Actinomyces as well as Streptococcus mutans required higher concentrations (27.4 mg/ml).
These results coincide with those found in the preliminary study carried out by the radial diffusion method in agar, where it was found that the ethanolic extract of X. poposum on Streptococcus, Actinomyces and Lactobacillus has higher relative inhibition percentages (between 90 and 140%) than on Candida and Veillonella for example, with inhibition percentages of approximately 80 and 40% [17]. Due to these differences, we could infer that the mechanism of action of this natural substance would be at the level of the cell wall.
In later stages, work is planned with Candida and the study of the mechanism of action of Xenophyllum poposum on bacteria and fungi.
This research aims to verify the efficacy of these regional extracts on cariogenic microorganisms with the goal of using this natural substance for preventive purposes, highlighting the value of these plants within the healthcare context of certain communities in the Argentine Republic, as an accessible and affordable resource for primary health care.
Any antimicrobial therapy applied to the oral cavity must be controlled to maintain the ecological balance of the resident microbiota, which contributes to host defenses by preventing the colonization of foreign species.
- Bermúdez L, Diaz G, Elena M (2016) Biofilm: A new conception of dental plaque. Medicentro Electrónica 20(3): 167-175.
- Cruz QSM, Sjostrom PD, Socarrás DA, Baldeón GM (2017) Microbiota of the oral cavity ecosystems. Cuban J Stomatol 54(1): 84-99.
- Santiago G, Sergio U (2022) Past, present and future of cariology. Int J Interdiscip Dent 15(3): 250-254.
- Marsh PD (2018) In Sickness and in Health-What Does the Oral Microbiome Mean to Us? An Ecological Perspective. Adv Dental Res 29(1): 60-65.
- Arreguín-Cano JA, Gerónimo CR, Bermúdez CH, Pérez OMF, Arroyo VJA, et al. (2016) Dental caries and caries-associated microorganisms in the saliva of first-year students at the Faculty of Dentistry, UNAM. Mexican Dental J 20(2): 77-81.
- Ojeda-Garcés JC, Oviedo GE, Salas LA (2013) Streptococcus mutans and dental caries. CES Dent 26(1): 44-56.
- Figueroa-GM, Acevedo, AM, Guillermina A (2009) Microorganisms present in the different stages of dental caries lesion progression. Venezuelan Dental Act 47(1): 227-240.
- Díaz-Reissner CV, Pérez-Bejarano NM, Sanabria-Vázquez DA, Ferreira-Gaona MI, Cueto-González NC, et al. (2016) Knowledge level on dental caries prevention among university students. CES Odontología 29(1): 14-21.
- Robertson PJ, Tofiño PME, Leyva HER, Parlange OA (2010) Current concepts and future research in the treatment of dental caries and plaque control. Mexican Dental J 14(4): 218-225.
- Xin X, Xue ZD, Wu CD (2011) The Tea Catechin Epigallocatechin Gallate Suppresses Cariogenic Virulence Factors of Streptococcus mutans. Antimicrob Agents Chemother 55(3): 1229-1236.
- Bernardi A, Teixeira CS (2015) The properties of chlorhexidine and undesired effects of its use in endodontics. Quintessence Int 46(7): 575-582.
- Rodrigues T, Reker D, Schneider P, Schneider G (2016) Counting on natural products for drug design. Nat Chem 8(6): 531-541.
- Valois-de-Sá TC, Neto VM, do-Carmo SCD, Costa-Ribeiro CC, Alves CCM (2020) Evaluation of the Antimicrobial Activity of Propolis-Based Dentifrices against Oral Pathogens. CES Dent 33(2): 12-22.
- González AM, Tracanna MI, Amani SM, Schuff C, Poch MJ, et al. (2012) Chemical composition, antimicrobial and antioxidant properties of the volatile oil and methanol extract of Xenophyllum poposum. Nat Prod Commun 7(12): 1663-1667.
- Carrillo CA, Rodríguez N, Rodríguez C (2010) In Vitro Evaluation of the Antibacterial Effect of Bidens Pilosa, Lantana Camara, Schinus Molle, and Silybum Marianum. U.D.C.A. J Curr Events Sci Dissem 13(2): 117-124.
- Trujillo CE (2002) Conditions for a good susceptibility study using agar diffusion testing. Chilean J Infectol 19suppl2: 77-81.
- Torres SC, de Ferro G, Inés M, Inés TM, Susana G (2022) Study of the antimicrobial activity of Xenophyllum poposum on oral cavity microorganisms by the radial diffusion method. Acta Bioquím Clín Latinoam 56 (1): 37-42.
- Raju KS, Moorthy K, Vinodhini R, Punitha T (2013) Antimicrobial Efficacy and Phytochemical Analysis of Indigofera Trita Afr J Tradit Complement Altern Med 10(3): 518-525.
- Struthers K, Westran R (2005) Clinical Bacteriology. Ed. Masson S.A. pp: 192.
- Devienne K, Raddi MS (2002) Screening for antimicrobial activity of natural products using a microplate photometer. Braz J Microb 33: 166-168.
- Pieri FA, Mussi MMC, Fiorini JE, Moreira SMA, Schneedorf JM (2012) Bacteriostatic effect of copaiba oil (Copaifera officinalis) against Streptococcus mutans. Braz Dental J 23(1): 36-38.
- Clinical and Laboratory Standards Institute (2007) Performance Standards for Antimicrobial Susceptibility Testing; Seventeenth Informational Supplement Vol 27(1).
- Arqueros CVM (2005) Specialization Thesis: In Vitro Growth Inhibition of Streptococcus mutans by Papain and Sanitrend. University of Chile, School of Dentistry.
- Sybiya IA, Packiavathy V, Agilandeswari P, Musthafa KS, Pandian SK, et al. (2012) Antibiofilm and quorum sensing inhibitory potential of Cuminum cyminum and its secondary metabolite methyl eugenol against gram-negative bacterial pathogens. Food Res Int 45: 85-92.














